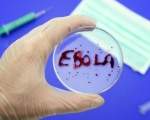

Главные новости страны ua-ru.info » Новости » В Либерии на новогоднюю ночь отменен комендантский час, введенный из-за Эболы
В Либерии на новогоднюю ночь отменен комендантский час, введенный из-за Эболы
В Либерии власти временно отменили комендантский час, введенный из-за вспышки лихорадки Эбола, чтобы позволить верующим посетить новогодние службы в церквях. Об этом сообщает BBC, пишет издание «112.ua».
При этом заместитель министра информации страны подчеркнул, что верующим следует избегать попадания в толпу и прикосновений друг к другу из-за риска заражения.
Либерийское общество – чрезвычайно религиозное, большую его часть составляют христиане.
Новости по теме: Первый случай заболевания Эболой зафиксирован в Шотландии
Напомним, по последним данным ВОЗ, жертвами вируса Эбола стали около 8 тыс. человек.
Просмотров: 1164; Комментариев: 0; Дата публикации: 17-01-2015, 15:07
Понравилась статья? Поделитесь ей с друзьями:
Рекомендуем похожее:
Число жертв вируса Эбола превысило 7,9 тыс. человек, - ВОЗ
пресс-служба Минобороны Украины Количество жертв лихорадки, вызванной вирусом Эбола, достигло
В Шотландии зафиксирован случай заражения Эбола
КИЕВ. 29 декабря. УНН. Правительство Шотландии подтвердило, что у одного из медработников
В Шотландии зафиксирован случай заражения Эболой
Правительство Шотландии подтвердило, что у одного из медработников диагностированалихорадка Эбола,
Первый случай заболевания Эболой зафиксирован в Шотландии
Фото из открытых источников В Шотландии зафиксирован первый случай заболевания лихорадкой
Эболу в Либерии больше не разрастаться
Президент Либерии Эллен Джонсон-Серлиф отменил чрезвычайное положение, введенное из-за вспышки
ВОЗ одобрила применение экспериментальных препаратов от лихорадки ЭБОЛА
Всемирная организация здравоохранения одобрила применение экспериментального препарата от
Рекомендуем
Популярные новости
Качественные автозапчасти для коммерческих моделей автомобилей — несколько причин обратиться в интернет-магазин «BUS-shop»
Ключевые особенности новостных сайтов
Ключевые преимущества новостных сайтов
Австралия запретила продажу РФ компонентов для производства оружия
Австралия предоставит Украине еще $15,5 млн военной помощи
США предложили Турции передать Украине российские С-400 - Reuters
Байден пригрозил КНР, если та станет помогать России
Boeing ввел запрет на использование самолетов грузоперевезчику РФ
Новостная лента
Общество
Ситуация в Донбассе: последние новости от ополчения и сила интернет-вестей
Ситуация в Донбассе: последние новости от ополчения и сила интернет-вестей
Ситуация в Донбассе: последние новости от ополчения и сила интернет-вестей
Удаленный доступ к рабочему столу: всё, что нужно знать
Удаленный доступ к рабочему столу: всё, что нужно знать
Австралия запретила продажу РФ компонентов для производства оружия
20-03-2022, 08:26
Речь идет о глиноземе и алюминиевой руде, которые являются важнейшими компонентами оружия и
Австралия предоставит Украине еще $15,5 млн военной помощи
20-03-2022, 05:58
Также Канберра обязалась выделить около 22 млн долларов на гуманитарную помощь гражданскому
США предложили Турции передать Украине российские С-400 - Reuters
20-03-2022, 04:07
Американская администрация призывала и другие страны поставить в Украину комплексы С-300 и С-400,
Виды футбольных манежей. Преимущества
27-10-2019, 14:33
Главная задача государства заключается в сохранении здоровья населения.

Добавить комментарий!